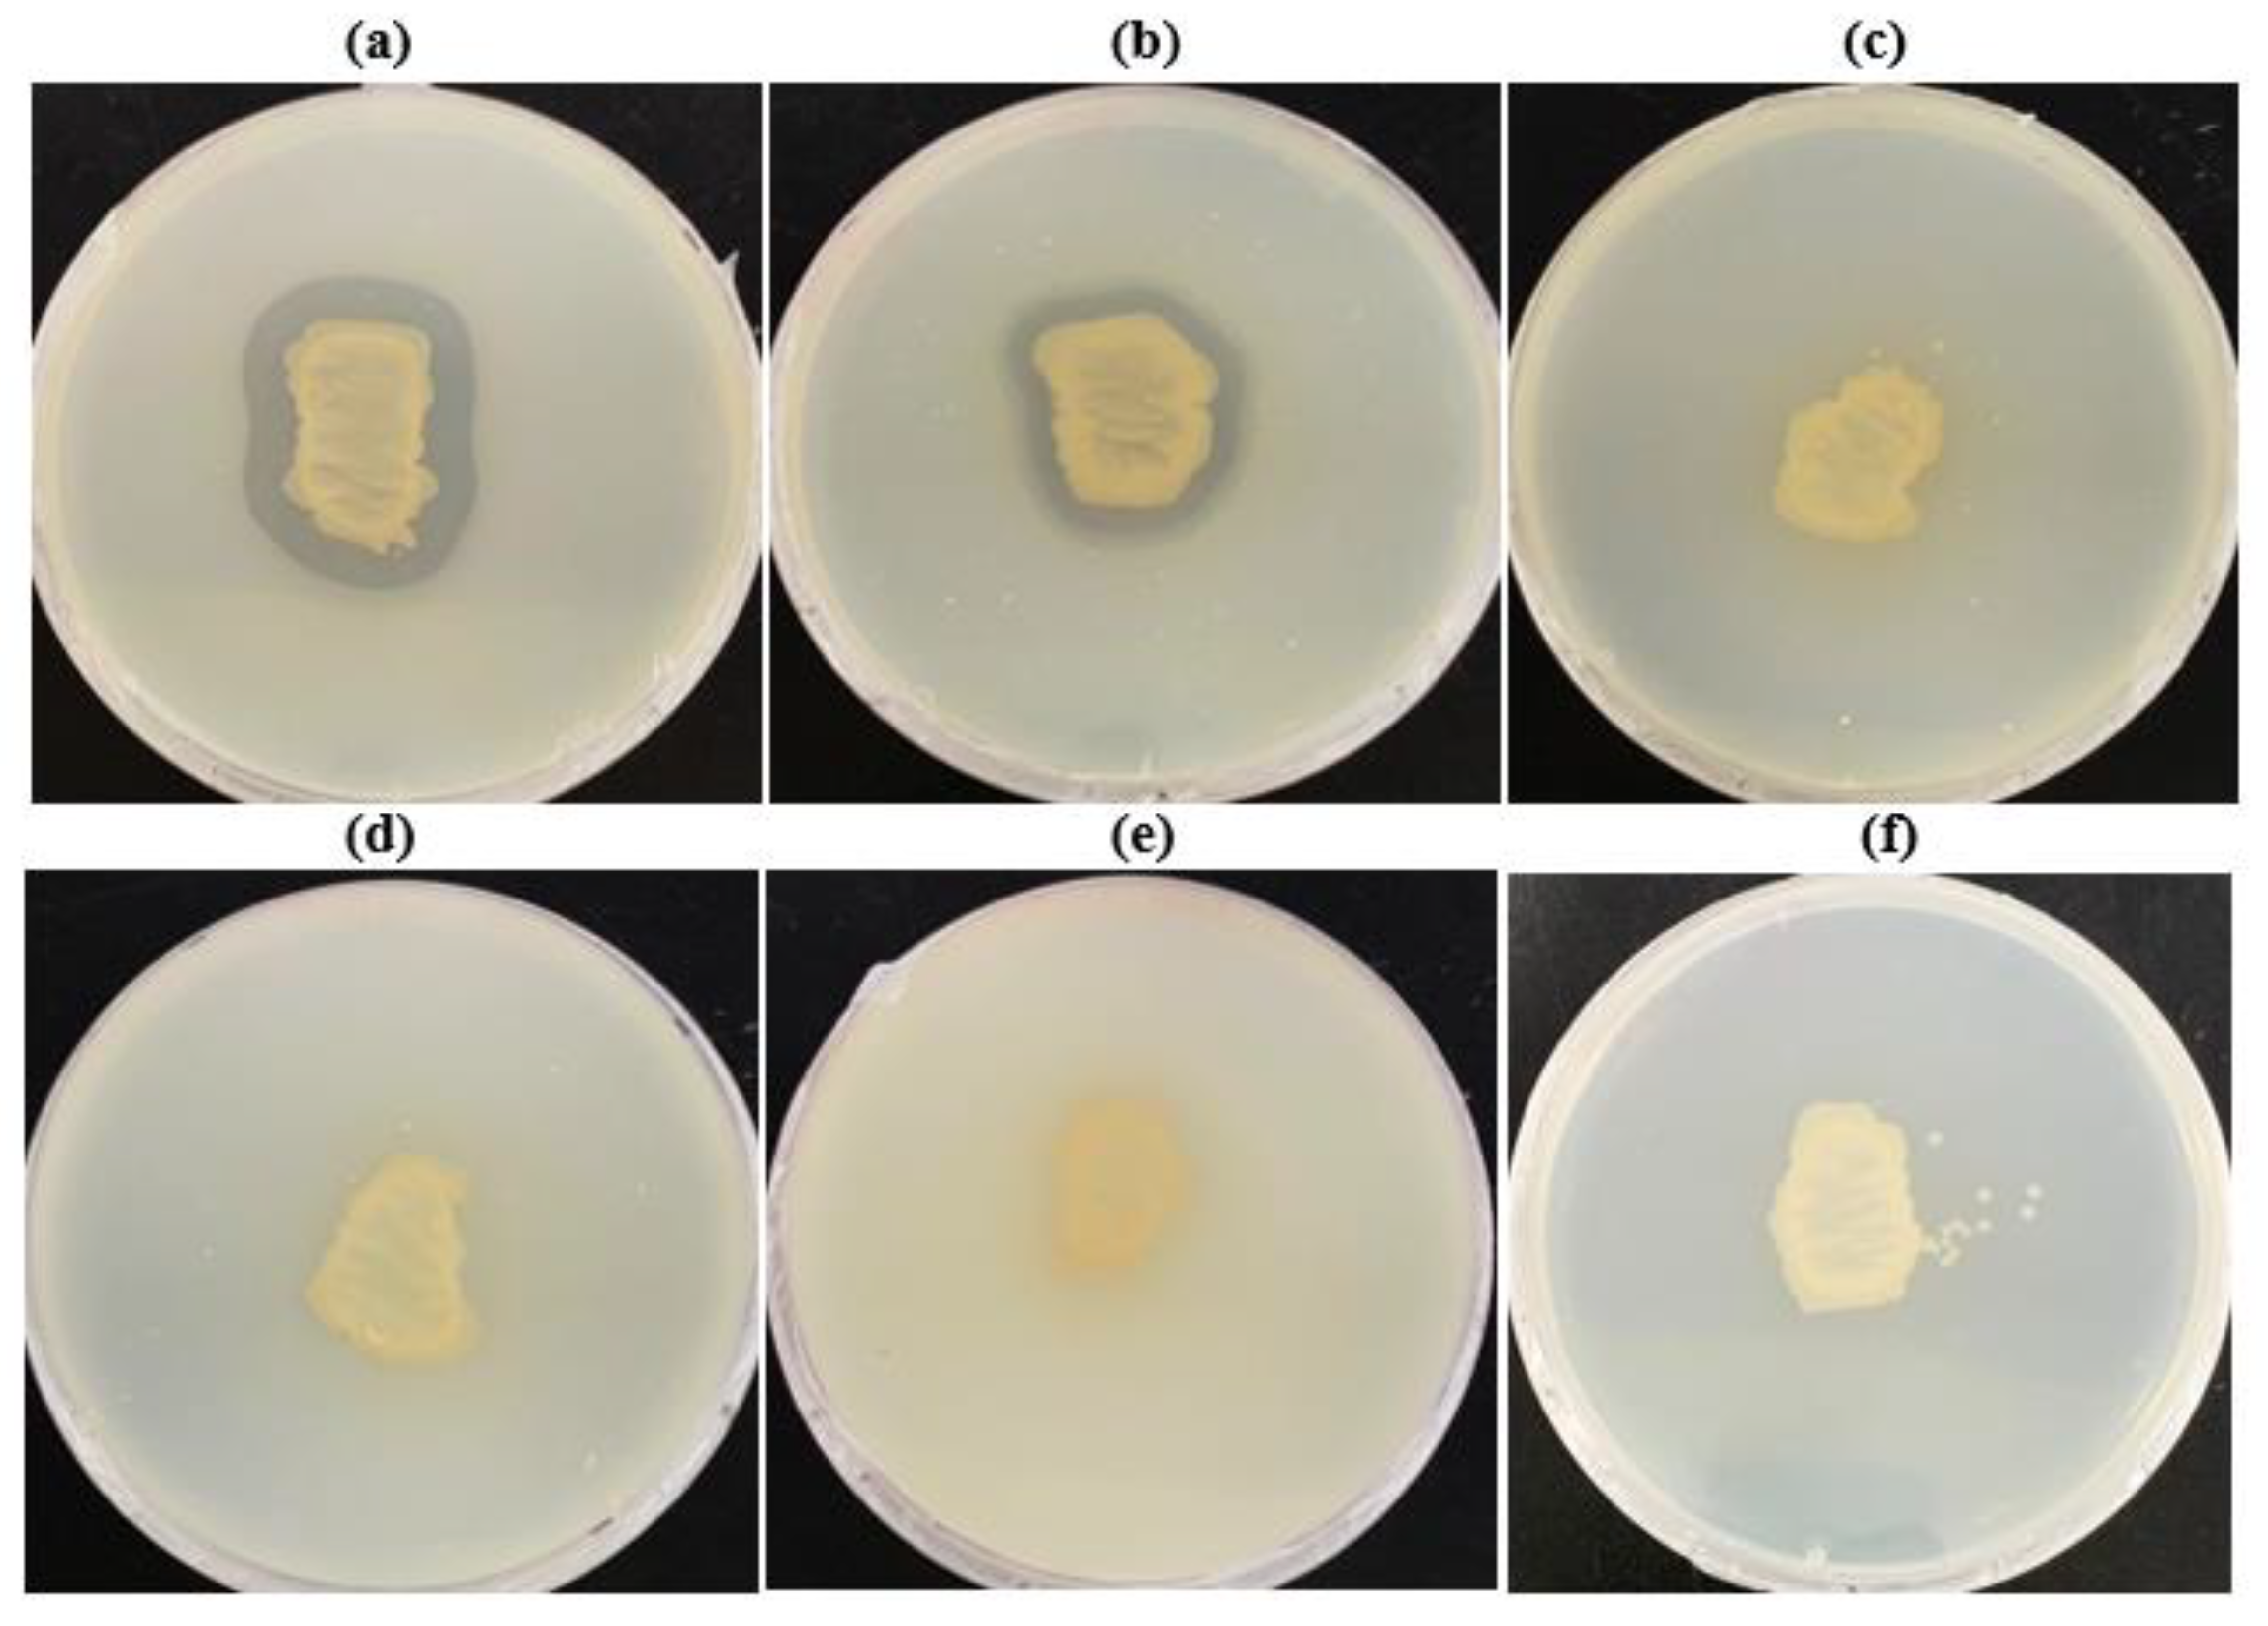

Isolation of Microbulbifer sp. SOL66 with High Polyhydroxyalkanoate-Degrading Activity from the Marine Environment
Abstract
:1. Introduction
2. Materials and Methods
2.1. Chemicals
2.2. 16S rRNA Sequencing and Phylogenetic Analysis
2.3. Preparation of Bioplastic-Emulsified Medium
2.4. PHB Degradation Assays
2.5. GC Analysis
2.6. Metabolite Analysis
2.7. Analysis of Physical Properties
2.8. Statistical Analysis
3. Results and Discussion
3.1. Isolation of PHB-Degrading Bacteria and Selection of Microbulbifer Genus
3.2. Optimal Conditions for Biodegradation
3.3. Physical Properties of PHB after Biodegradation
3.4. Biodegradability of Other Bioplastics by Microbulbifer sp. SOL66
4. Conclusions
Supplementary Materials
Author Contributions
Funding
Institutional Review Board Statement
Informed Consent Statement
Data Availability Statement
Conflicts of Interest
References
- Emadian, S.M.; Onay, T.T.; Demirel, B. Biodegradation of Bioplastics in Natural Environments. Waste Manag. 2017, 59, 526–536. [Google Scholar] [CrossRef]
- Sabbagh, F.; Muhamad, I.I. Production of Poly-Hydroxyalkanoate as Secondary Metabolite with Main Focus on Sustainable Energy. Renew. Sustain. Energy Rev. 2017, 72, 95–104. [Google Scholar] [CrossRef]
- Mojaveryazdi, F.; Zain, N.; Rezania, S. Production of Biodegradable Polymers (PHA) through Low Cost Carbon Sources:Green Chemistry. Int. J. Chem. Environ. Eng. 2012, 4, 185–189. [Google Scholar]
- Romen, F.; Reinhardt, S.; Jendrossek, D. Thermotolerant Poly(3-Hydroxybutyrate)-Degrading Bacteria from Hot Compost and Characterization of the PHB Depolymerase of Schlegellella Sp. KB1a. Arch. Microbiol. 2004, 182, 157–164. [Google Scholar] [CrossRef]
- Jendrossek, D.; Knoke, I.; Habibian, R.B.; Steinbüchel, A.; Schlegel, H.G. Degradation of Poly(3-Hydroxybutyrate), PHB, by Bacteria and Purification of a Novel PHB Depolymerase from Comamonas Sp. J. Environ. Polym. Degrad. 1993, 1, 53–63. [Google Scholar] [CrossRef]
- Mukai, K.; Yamada, K.; Doi, Y. Kinetics and Mechanism of Heterogeneous Hydrolysis of Poly[(R)-3-Hydroxybutyrate] Film by PHA Depolymerases. Int. J. Biol. Macromol. 1993, 15, 361–366. [Google Scholar] [CrossRef]
- Kasuya, K.I.; Inoue, Y.; Yamada, K.; Doi, Y. Kinetics of Surface Hydrolysis of Poly[(R)-3-Hydroxybutyrate] Film by PHB Depolymerase from Alcaligenes Faecalis T1. Polym. Degrad. Stab. 1995, 48, 167–174. [Google Scholar] [CrossRef]
- González, J.M.; Mayer, F.; Moran, M.A.; Hodson, R.E.; Whitman, W.B. Microbulbifer hydrolyticus Gen. Nov., Sp. Nov., and Marinobacterium georgiense Gen. Nov., Sp. Nov., Two Marine Bacteria from a Lignin-Rich Pulp Mill Waste Enrichment Community. Int. J. Syst. Bacteriol. 1997, 47, 369–376. [Google Scholar] [CrossRef] [PubMed] [Green Version]
- Nishijima, M.; Takadera, T.; Imamura, N.; Kasai, H.; An, K.D.; Adachi, K.; Nagao, T.; Sano, H.; Yamasato, K. Microbulbifer variabilis Sp. Nov. and Microbulbifer epialgicus Sp. Nov., Isolated from Pacific Marine Algae, Possess a Rod-Coccus Cell Cycle in Association with the Growth Phase. Int. J. Syst. Evol. Microbiol. 2009, 59, 1696–1707. [Google Scholar] [CrossRef]
- Li, Z.; Wei, R.; Gao, M.; Ren, Y.; Yu, B.; Nie, K.; Xu, H.; Liu, L. Biodegradation of Low-Density Polyethylene by Microbulbifer hydrolyticus IRE-31. J. Environ. Manag. 2020, 263, 110402. [Google Scholar] [CrossRef] [PubMed]
- Uchida, H.; Nakajima-Kambe, T.; Shigeno-Akutsu, Y.; Nomura, N.; Tokiwa, Y.; Nakahara, T. Properties of a Bacterium Which Degrades Solid Poly(Tetramethylene Succinate)-Co-Adipate, a Biodegradable Plastic. FEMS Microbiol. Lett. 2000, 189, 25–29. [Google Scholar] [CrossRef] [PubMed]
- Park, Y.L.; Bhatia, S.K.; Gurav, R.; Choi, T.R.; Kim, H.J.; Song, H.S.; Park, J.Y.; Han, Y.H.; Lee, S.M.; Park, S.L.; et al. Fructose Based Hyper Production of Poly-3-Hydroxybutyrate from Halomonas Sp. YLGW01 and Impact of Carbon Sources on Bacteria Morphologies. Int. J. Biol. Macromol. 2020, 154, 929–936. [Google Scholar] [CrossRef]
- Park, S.L.; Cho, J.Y.; Choi, T.R.; Song, H.S.; Bhatia, S.K.; Gurav, R.; Park, S.H.; Park, K.; Joo, J.C.; Hwang, S.Y.; et al. Improvement of Polyhydroxybutyrate (PHB) Plate-Based Screening Method for PHB Degrading Bacteria Using Cell-Grown Amorphous PHB and Recovered by Sodium Dodecyl Sulfate (SDS). Int. J. Biol. Macromol. 2021, 177, 413–421. [Google Scholar] [CrossRef]
- Jung, H.R.; Choi, T.R.; Han, Y.H.; Park, Y.L.; Park, J.Y.; Song, H.S.; Yang, S.Y.; Bhatia, S.K.; Gurav, R.; Park, H.A.; et al. Production of Blue-Colored Polyhydroxybutyrate (PHB) by One-Pot Production and Coextraction of Indigo and PHB from Recombinant Escherichia coli. Dyes Pigment. 2020, 173, 107889. [Google Scholar] [CrossRef]
- Bhatia, S.K.; Yoon, J.J.; Kim, H.J.; Hong, J.W.; Gi Hong, Y.; Song, H.S.; Moon, Y.M.; Jeon, J.M.; Kim, Y.G.; Yang, Y.H. Engineering of Artificial Microbial Consortia of Ralstonia eutropha and Bacillus subtilis for Poly(3-Hydroxybutyrate-Co-3-Hydroxyvalerate) Copolymer Production from Sugarcane Sugar without Precursor Feeding. Bioresour. Technol. 2018, 257, 92–101. [Google Scholar] [CrossRef] [PubMed]
- Cho, J.Y.; Lee Park, S.; Lee, H.J.; Kim, S.H.; Suh, M.J.; Ham, S.; Bhatia, S.K.; Gurav, R.; Park, S.H.; Park, K.; et al. Polyhydroxyalkanoates (PHAs) Degradation by the Newly Isolated Marine bacillus Sp. JY14. Chemosphere 2021, 283, 131172. [Google Scholar] [CrossRef] [PubMed]
- Braunegg, G.; Sonnleitner, B.; Lafferty, R.M. A Rapid Gas Chromatographic Method for the Determination of Poly-β-Hydroxybutyric Acid in Microbial Biomass. Eur. J. Appl. Microbiol. Biotechnol. 1978, 6, 29–37. [Google Scholar] [CrossRef]
- Hong, Y.G.; Moon, Y.M.; Hong, J.W.; Choi, T.R.; Jung, H.R.; Yang, S.Y.; Jang, D.W.; Park, Y.R.; Brigham, C.J.; Kim, J.S.; et al. Discarded Egg Yolk as an Alternate Source of Poly(3-Hydroxybutyrate-Co-3-Hydroxyhexanoate). J. Microbiol. Biotechnol. 2019, 29, 382–391. [Google Scholar] [CrossRef] [PubMed]
- Jung, H.R.; Lee, J.H.; Moon, Y.M.; Choi, T.R.; Yang, S.Y.; Song, H.S.; Park, J.Y.; Park, Y.L.; Bhatia, S.K.; Gurav, R.; et al. Increased Tolerance to Furfural by Introduction of Polyhydroxybutyrate Synthetic Genes to Escherichia coli. J. Microbiol. Biotechnol. 2019, 29, 776–784. [Google Scholar] [CrossRef]
- Jung, H.R.; Yang, S.Y.; Moon, Y.M.; Choi, T.R.; Song, H.S.; Bhatia, S.K.; Gurav, R.; Kim, E.J.; Kim, B.G.; Yang, Y.H. Construction of Efficient Platform Escherichia coli Strains for Polyhydroxyalkanoate Production by Engineering Branched Pathway. Polymers 2019, 11, 509. [Google Scholar] [CrossRef] [PubMed] [Green Version]
- Song, H.S.; Bhatia, S.K.; Choi, T.R.; Gurav, R.; Kim, H.J.; Lee, S.M.; Park, S.L.; Lee, H.S.; Joo, H.S.; Kim, W.; et al. Increased Antibiotic Resistance of Methicillin-Resistant Staphylococcus aureus USA300 Δpsm Mutants and a Complementation Study of Δpsm Mutants Using Synthetic Phenol-Soluble Modulins. J. Microbiol. Biotechnol. 2021, 31, 115–122. [Google Scholar] [CrossRef] [PubMed]
- Bhatia, S.K.; Gurav, R.; Choi, T.R.; Jung, H.R.; Yang, S.Y.; Song, H.S.; Jeon, J.M.; Kim, J.S.; Lee, Y.K.; Yang, Y.H. Poly(3-Hydroxybutyrate-Co-3-Hydroxyhexanoate) Production from Engineered Ralstonia Eutropha Using Synthetic and Anaerobically Digested Food Waste Derived Volatile Fatty Acids. Int. J. Biol. Macromol. 2019, 133, 1–10. [Google Scholar] [CrossRef]
- Gurav, R.; Bhatia, S.K.; Choi, T.R.; Park, Y.L.; Park, J.Y.; Han, Y.H.; Vyavahare, G.; Jadhav, J.; Song, H.S.; Yang, P.; et al. Treatment of Furazolidone Contaminated Water Using Banana Pseudostem Biochar Engineered with Facile Synthesized Magnetic Nanocomposites. Bioresour. Technol. 2020, 297, 122472. [Google Scholar] [CrossRef]
- Kuchta, K.; Chi, L.; Fuchs, H.; Pötter, M.; Steinbüchel, A. Studies on the Influence of Phasins on Accumulation and Degradation of PHB and Nanostructure of PHB Granules in Raistonia eutropha H16. Biomacromolecules 2007, 8, 657–662. [Google Scholar] [CrossRef] [PubMed]
- Choi, T.R.; Jeon, J.M.; Bhatia, S.K.; Gurav, R.; Han, Y.H.; Park, Y.L.; Park, J.Y.; Song, H.S.; Park, H.Y.; Yoon, J.J.; et al. Production of Low Molecular Weight P(3HB-Co-3HV) by Butyrateacetoacetate CoA-Transferase (CftAB) in Escherichia coli. Biotechnol. Bioprocess Eng. 2020, 25, 279–286. [Google Scholar] [CrossRef]
- Manna, A.; Paul, A.K. Degradation of Microbial Polyester Poly(3-Hydroxybutyrate) in Environmental Samples and in Culture. Biodegradation 2000, 11, 323–329. [Google Scholar] [CrossRef] [PubMed]
- Lodhi, A.F.; Hasan, F.; Shah, Z.; Hameed, A.; Faisal, S.; Shah, A.A. Optimization of Culture Conditions for the Production of Poly (3-Hydroxybutyrate) Depolymerase from Newly Isolated Aspergillus fumigatus from Soil. Pak. J. Bot. 2011, 43, 1361–1372. [Google Scholar]
- Vigneswari, S.; Lee, T.S.; Bhubalan, K.; Amirul, A.A. Extracellular Polyhydroxyalkanoate Depolymerase by Acidovorax Sp. DP5. Enzym. Res. 2015, 2015, 212159. [Google Scholar] [CrossRef] [Green Version]
- Kasuya, K.I.; Inoue, Y.; Doi, Y. Adsorption Kinetics of Bacterial PHB Depolymerase on the Surface of Polyhydroxyalkanoate Films. Int. J. Biol. Macromol. 1996, 19, 35–40. [Google Scholar] [CrossRef]
- Iwata, T.; Doi, Y.; Kasuya, K.I.; Inoue, Y. Visualization of Enzymatic Degradation of Poly[(R)-3-Hydroxybutyrate] Single Crystals by an Extracellular PHB Depolymerase. Macromolecules 1997, 30, 833–839. [Google Scholar] [CrossRef]
- Pattanasuttichonlakul, W.; Sombatsompop, N.; Prapagdee, B. Accelerating Biodegradation of PLA Using Microbial Consortium from Dairy Wastewater Sludge Combined with PLA-Degrading Bacterium. Int. Biodeterior. Biodegrad. 2018, 132, 74–83. [Google Scholar] [CrossRef]
- Speight, J.G. Handbook of Industrial Hydrocarbon Processes; James, G., Ed.; Elsevier: Amsterdam, The Netherlands, 2011. [Google Scholar]
- Amund, O.O.; Adebiyi, A.G. Effect of Viscosity on the Biodegradability of Automotive Lubricating Oils. Tribol. Int. 1991, 24, 235–237. [Google Scholar] [CrossRef]

| Isolates | Similar Strain | Identity |
|---|---|---|
| SOL03 | Microbulbifer taiwanensis | 95.81% |
| SOL51 | Microbulbifer aestuariivivens | 94.18% |
| SOL55 | Microbulbifer salipaludis | 80.01% |
| SOL66 | Microbulbifer hydrolyticus | 95.15% |
| SOL84 | Microbulbifer elonatus | 97.01% |
| Mw (×103) | Mn (×103) | Mw/Mn (PDI) | |
|---|---|---|---|
| Control | 587 | 438 | 1.34 |
| 3 days | 319 | 57 | 5.56 |
| 5 days | 220 | 40 | 5.53 |
| 7 days | 194 | 35 | 5.59 |
Publisher’s Note: MDPI stays neutral with regard to jurisdictional claims in published maps and institutional affiliations. |
© 2021 by the authors. Licensee MDPI, Basel, Switzerland. This article is an open access article distributed under the terms and conditions of the Creative Commons Attribution (CC BY) license (https://creativecommons.org/licenses/by/4.0/).
Share and Cite
Park, S.L.; Cho, J.Y.; Kim, S.H.; Bhatia, S.K.; Gurav, R.; Park, S.-H.; Park, K.; Yang, Y.-H. Isolation of Microbulbifer sp. SOL66 with High Polyhydroxyalkanoate-Degrading Activity from the Marine Environment. Polymers 2021, 13, 4257. https://doi.org/10.3390/polym13234257
Park SL, Cho JY, Kim SH, Bhatia SK, Gurav R, Park S-H, Park K, Yang Y-H. Isolation of Microbulbifer sp. SOL66 with High Polyhydroxyalkanoate-Degrading Activity from the Marine Environment. Polymers. 2021; 13(23):4257. https://doi.org/10.3390/polym13234257
Chicago/Turabian StylePark, Sol Lee, Jang Yeon Cho, Su Hyun Kim, Shashi Kant Bhatia, Ranjit Gurav, See-Hyoung Park, Kyungmoon Park, and Yung-Hun Yang. 2021. "Isolation of Microbulbifer sp. SOL66 with High Polyhydroxyalkanoate-Degrading Activity from the Marine Environment" Polymers 13, no. 23: 4257. https://doi.org/10.3390/polym13234257
APA StylePark, S. L., Cho, J. Y., Kim, S. H., Bhatia, S. K., Gurav, R., Park, S.-H., Park, K., & Yang, Y.-H. (2021). Isolation of Microbulbifer sp. SOL66 with High Polyhydroxyalkanoate-Degrading Activity from the Marine Environment. Polymers, 13(23), 4257. https://doi.org/10.3390/polym13234257

